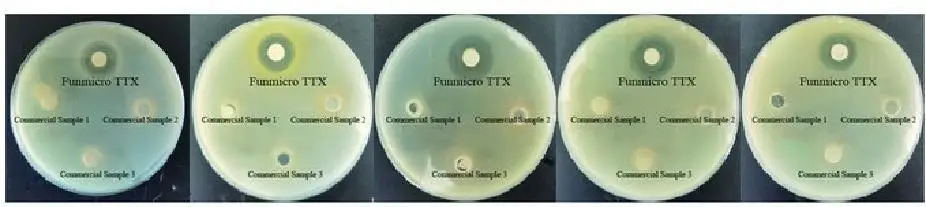
Fun Micro 1-2

fish probiotics biofloc bacillus subtilis capsules
- Category: >>>
- Supplier: Shandong Tianrunhe Bio-Engineering Co. Ltd.
Share on (1600909738580):
Product Overview
Description
fish probiotics biofloc bacillus subtilis capsules
The bacillus subtilis contained in this product is a safe and non-toxic intestinal probiotic with a wide antibacterial spectrum, strong antibac- terial ability, and screening from thousands of animal intestinal microorganisms. After the intestinal microecological diversity analysis, high-throughput screening and antibacterial spectrum analysis technology. It is wide antibacterial spectrum, strong antibacterial ability,
safety and non-toxicity.
Studies have shown that the K18 strain and its products will be the best solution for a new generation of feed replacement antibiotics.
Name | Funmicro TTX |
Specification | 10billion-50billion CFU/g |
Form | Soluble powder, insoluble powder |
Color | Light brown |
Component | Bacillus subtilis, metabolites of Bacillus subtilis and carrier |
Packaging | 25kg/bag |
Shelf life | 18 months |
Storage | Sealed package in a cool, dry and ventilated place. |
Dosage(10 Billion CFU/g)
This product is mixed with other additives or auxiliary materials as a premixed material, and then added to the powder after premixed or directly pelleted and fed with other feed materials.
Poultry:100-300g/t
Suckling pig: 200-300g/t
Fattening pig:100- 150g/t
Notes
1. Mix well when used, dosage may be increased appropriately during the illness.
2. Avoid disinfection and antibacterial drugs during use.
Product Features
1. Storage stability
12 months of conventional storage of Funmicro TTX product, the bacterial content only lost 4%.

Figure 3 Storage stability of Funmicro TTX product
Strain Characteristics
1. Significant antibacterial effect by plate culture
Shigella Dysenteriae
Figure 1 Antibacterial effect on different pathogenic bacteria
It can be seen from Figure 1 that Funmicro TTX (K18 strain) has a very significant inhibitory effect on four common pathogenic bacteria, which can greatly reduce the occurrence of diseases in the breeding process, ensure the healthy growth of animals, and bring more benefits to farmers.
2. Germination rate

Figure 2 Germination rate of spores
It can be seen from Figure 2 that the Funmicro TTX K18 strain has started to grow in 2 hours, and entered the logarithmic growth phase in 6 hours, and the growth rate is much higher than that of commercially available product strains. After entering the intestinal tract, it can quickly germinate and form a dominant bacterial flora.
3. Enzyme production performance
| Strain | Zymogram after incubation for 36 hours | |||
Protease | Amylase | Cellulase | Lipase | |
| K18 strain | 4 | 4 | 1 | 2 |
| Commercial similar strain | 2 | 2 | ||





We Recommend
New Arrivals
New products from manufacturers at wholesale prices




















